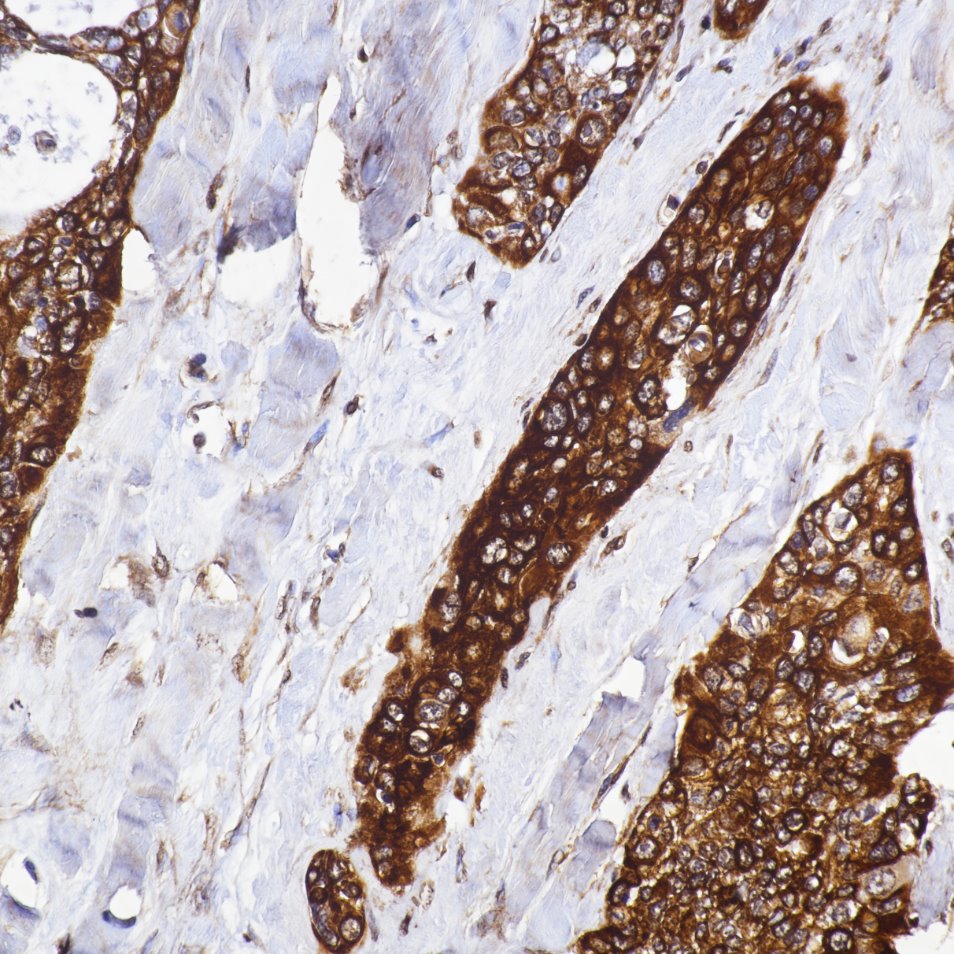
Immunohistochemistry (IHC) staining of human lung cancer tissue using VEGFA Monoclonal antibody (66828-1-Ig)

Tested Applications
| Positive WB detected in | MCF-7 cells, HUVEC cells, NCI-H1299 cells, A431 cells, SH-SY5Y cells, HuH-7 cells, T-47D cells, MDA-MB-231 cells |
| Positive IHC-Autostainer detected in | human Lung Cancer tissue |
| Positive IHC detected in | human lung cancer tissue, human colon cancer tissue, human liver cancer tissue, human pancreas cancer tissue Note: suggested antigen retrieval with TE buffer pH 9.0; (*) Alternatively, antigen retrieval may be performed with citrate buffer pH 6.0 |
| Positive IF-P detected in | human endometrial cancer tissue, human lung cancer tissue |
| Positive IF/ICC detected in | MCF-7 cells |
| Positive FC (Intra) detected in | MCF-7 cells |
Recommended dilution
| Application | Dilution |
|---|---|
| Western Blot (WB) | WB : 1:1000-1:4000 |
| Immunohistochemistry (IHC)-AUTOSTAINER | IHC-AUTOSTAINER : 1:50-1:500 |
| Immunohistochemistry (IHC) | IHC : 1:500-1:2000 |
| Immunofluorescence (IF)-P | IF-P : 1:200-1:800 |
| Immunofluorescence (IF)/ICC | IF/ICC : 1:200-1:800 |
| Flow Cytometry (FC) (INTRA) | FC (INTRA) : 0.50 ug per 10^6 cells in a 100 µl suspension |
| It is recommended that this reagent should be titrated in each testing system to obtain optimal results. | |
| Sample-dependent, Check data in validation data gallery. | |
Published Applications
| KD/KO | See 3 publications below |
| WB | See 134 publications below |
| IHC | See 26 publications below |
| IF | See 31 publications below |
| ELISA | See 2 publications below |
Product Information
66828-1-Ig targets VEGFA in WB, IHC, IHC-Autostainer, IF/ICC, IF-P, FC (Intra), ELISA applications and shows reactivity with human samples.
| Tested Reactivity | human |
| Cited Reactivity | human, rat, pig, rabbit, zebrafish, goat |
| Host / Isotype | Mouse / IgG2b |
| Class | Monoclonal |
| Type | Antibody |
| Immunogen |
CatNo: Ag13500 Product name: Recombinant human VEGFA protein Source: e coli.-derived, PET28a Tag: 6*His Domain: 1-302 aa of BC065522 Sequence: AAASRGQGPEPAPGGGVEGVGARGVALKLFVQLLGCSRFGGAVVRAGEAEPSGAARSASSGREEPQPEEGEEEEEKEEERGPQWRLGARKPGSWTGEAAVCADSAPAARAPQALARASGRGGRVARRGAEESGPPHSPSRRGSASRAGPGRASETMNFLLSWVHWSLALLLYLHHAKWSQAAPMAEGGGQNHHEVVKFMDVYQRSYCHPIETLVDIFQEYPDEIEYIFKPSCVPLMRCGGCCNDEGLECVPTEESNITMQIMRIKPHQGQHIGEMSFLQHNKCECRPKKDRARQEKCDKPRR Predict reactive species |
| Full Name | vascular endothelial growth factor A |
| Calculated Molecular Weight | 412 aa, 46 kDa |
| Observed Molecular Weight | 43 kDa |
| GenBank Accession Number | BC065522 |
| Gene Symbol | VEGFA |
| Gene ID (NCBI) | 7422 |
| RRID | AB_2882171 |
| Conjugate | Unconjugated |
| Form | Liquid |
| Purification Method | Protein A purification |
| UNIPROT ID | P15692 |
| Storage Buffer | PBS with 0.02% sodium azide and 50% glycerol, pH 7.3. |
| Storage Conditions | Store at -20°C. Stable for one year after shipment. Aliquoting is unnecessary for -20oC storage. 20ul sizes contain 0.1% BSA. |
Background Information
VEGFA, also named as VEGF or VPF, belongs to the PDGF/VEGF growth factor family. It is a growth factor active in angiogenesis, vasculogenesis and endothelial cell growth. VEGFA induces endothelial cell proliferation, promotes cell migration, inhibits apoptosis and induces permeabilization of blood vessels. It binds to the FLT1/VEGFR1 and KDR/VEGFR2 receptors, heparan sulfate and heparin. Defects in VEGFA are associated with microvascular complications of diabetes type 1 (MVCD1). VEGFA has 17 isoforms with MW from 16 to 45 kDa. Some isoforms have homodimer forms (e.g.; VEGFA189 38kDa or VEFGA110 34 kDa). VEGF-A exists in at least seven homodimeric isoforms. The monomers consist of 121, 145, 148, 165, 183, 189, or 206 amino acids (PMID:15602010 ). This antibody can recognize all VEGFA isoforms.
Protocols
| Product Specific Protocols | |
|---|---|
| FC protocol for VEGFA antibody 66828-1-Ig | Download protocol |
| IF protocol for VEGFA antibody 66828-1-Ig | Download protocol |
| IHC protocol for VEGFA antibody 66828-1-Ig | Download protocol |
| WB protocol for VEGFA antibody 66828-1-Ig | Download protocol |
| Standard Protocols | |
|---|---|
| Click here to view our Standard Protocols |
Publications
| Species | Application | Title |
|---|---|---|
Signal Transduct Target Ther Aberrant Notch-signaling promotes tumor angiogenesis in esophageal squamous-cell carcinoma | ||
ACS Nano Inhalation of Mesenchymal-Stem-Cell-Derived Nanovesicles Delivering Catalase Enhances the Treatment for Acute Lung Injury | ||
Adv Sci (Weinh) Spatiotemporal Characterization of Human Early Intervertebral Disc Formation at Single-Cell Resolution | ||
J Nanobiotechnology Injectable HAMA-CPC hydrogels loaded with high-yield 3D bioprinted adipose-derived stem cell small extracellular vesicles for increased bone repair | ||
Redox Biol Nox2 impairs VEGF-A-induced angiogenesis in placenta via mitochondrial ROS-STAT3 pathway.
| ||
Reviews
The reviews below have been submitted by verified Proteintech customers who received an incentive for providing their feedback.
FH Grace (Verified Customer) (01-31-2025) | Works great for immunofluorescence (1:200), but I've had issues with western blotting. Only very faint bands show up in samples I know have high protein levels.
|